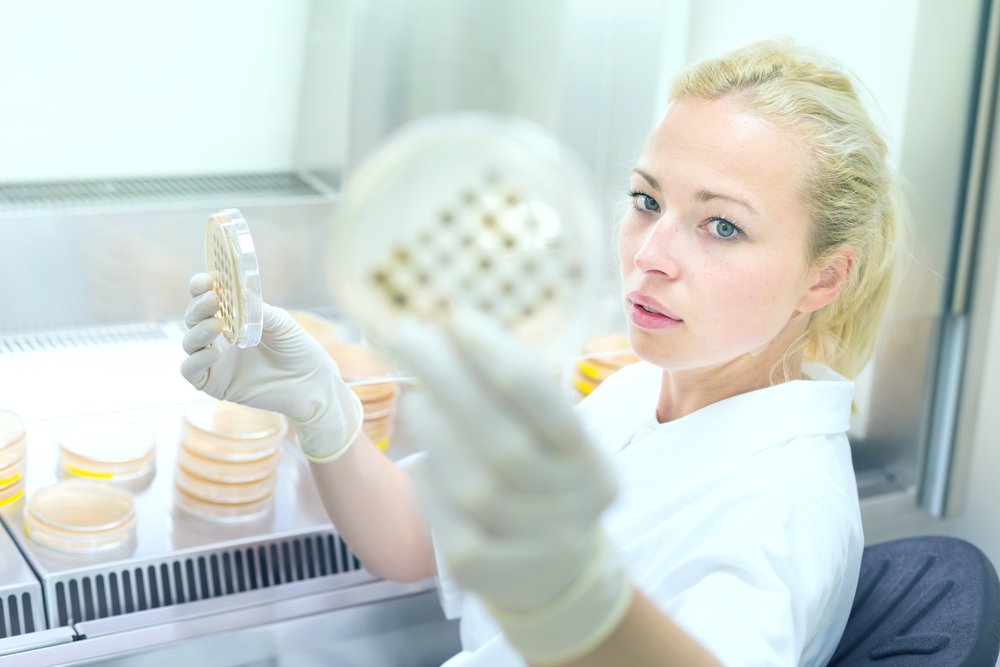

Tech Pulse
@Tech_Pulse_
Curated News and Insights on the fast paced #Startup world.
Potrebbero piacerti
The live streaming #app where musicians perform + engage with you in real time: tiny.cc/BestMusicApp #music

CloudFlare’s New Domain Registry Protects Site Owners From Domain Hijacking puls.ly/za2b1Q

Ex-Uber Public Policy Chief Corey Owens Is Now Working for Drone Giant DJI puls.ly/zaTnJA #technews

Twitter’s problem isn’t the timeline, it’s that signing up still sucks puls.ly/Mw57Eg #webnews

Activision Blizzard Closes Its $5.9B Acquisition Of King, Makers Of Candy Crush puls.ly/DtdRog

IBM Inks VMware, GitHub, Bitly Deals, Expands Apple Swift Use As It Doubles Do.. puls.ly/FyP9uA

Motosumo Turns Your Smartphone Into A Sports Tracker Without Need For Addition.. puls.ly/0mj62w

Triptease, The Startup That Helps Hotels Increase Direct Sales, Closes $7M Ser.. puls.ly/6eqnsw

IBM Acquiring Truven Health Analytics For $2.6 Billion And Adding It To Watson.. puls.ly/LVWCUg
Flint Mobile Payments Go Offline, Tells Customers To Use Stripe To Continue Se.. puls.ly/V6LxVQ

Mashable’s Very Big Meryl Streep Correction Missing From Facebook’s Instant Ar.. puls.ly/lmkc6Q #recode

United States Tendenze
- 1. #WWERaw 28.8K posts
- 2. Chiefs 57.3K posts
- 3. Mariota 5,939 posts
- 4. Maxey 4,873 posts
- 5. Glasnow 4,861 posts
- 6. Kelce 9,422 posts
- 7. #RaiseHail 5,189 posts
- 8. Mahomes 16.6K posts
- 9. Lattimore 2,606 posts
- 10. Edman 2,675 posts
- 11. Deebo 4,887 posts
- 12. Sixers 8,738 posts
- 13. #WorldSeries 40.3K posts
- 14. Alejandro Kirk 4,884 posts
- 15. Scary Terry 1,110 posts
- 16. #Commanders 2,014 posts
- 17. Pistons 7,031 posts
- 18. #MondayNightFootball N/A
- 19. Freddie 7,874 posts
- 20. Ertz 2,699 posts
Potrebbero piacerti
-
 David Cohen
David Cohen
@davidcohen -
 Josh Stein
Josh Stein
@JoshSteinVC -
 American Management Association
American Management Association
@AMAnet -
 Boomtown Innovation
Boomtown Innovation
@Boomtown -
 La France au Canada 🇫🇷 🇪🇺
La France au Canada 🇫🇷 🇪🇺
@franceaucanada -
 Jeff Sheehan Author | Mktg Consultant | Speaker
Jeff Sheehan Author | Mktg Consultant | Speaker
@jeffsheehan -
 eThrive
eThrive
@eThrive -
 Beau Laskey
Beau Laskey
@beaulaskey -
 Brett A. Cenkus
Brett A. Cenkus
@bcenkus -
 Alan R Schwartz
Alan R Schwartz
@schwartz_alanr -
 Antonello
Antonello
@hack_the_cloud -
 Mark Zabala 🤖👽🦄🎧
Mark Zabala 🤖👽🦄🎧
@MarkZabala
Something went wrong.
Something went wrong.














































































































